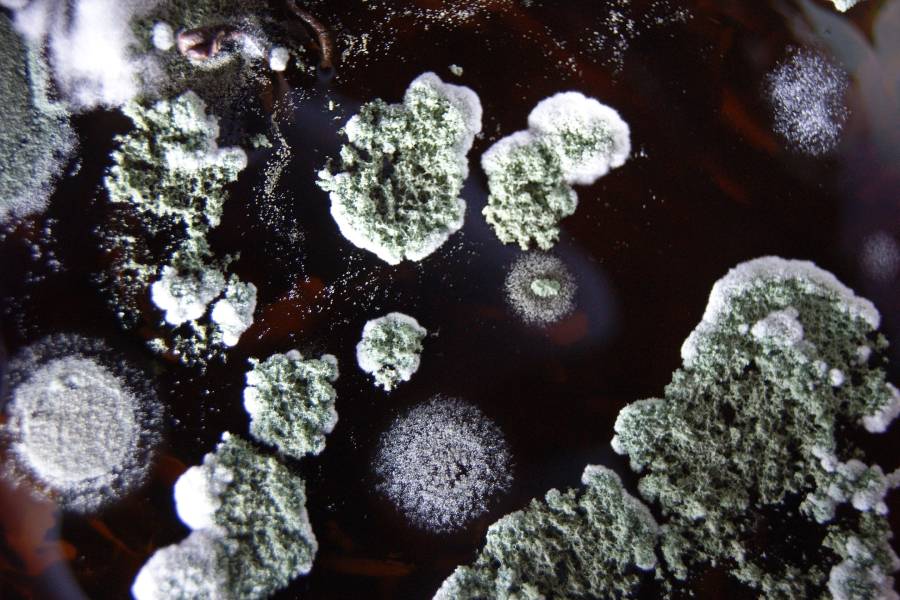

Астма, проблемы с легкими, грибок на теле и другие заболевания. Что такое домашняя плесень, чем она опасна и как с ней бороться
По данным Национального института наук о гигиене окружающей среды Северной Каролины, в мире существует больше полутора миллионов видов плесени. Некоторые из них могут разрастаться в жилых помещениях — и представлять опасность для людей и животных. «Такие дела» поговорили с экспертами о том, какие заболевания вызывают плесневые грибы и как с ними бороться.
 Плесень под микроскопом Фото: Давид Андронов / wikipedia.org
Плесень под микроскопом Фото: Давид Андронов / wikipedia.org Несколько лет назад на кафедру ботаники и микологии, где работает кандидат биологических наук Гавриил Мелькумов, обратилась семья из Воронежа. В их квартире на обоях появилось небольшое пятнышко черной плесени. После этого вся семья начала кашлять. Когда на место приехали микологи, они обнаружили, что под обоями плесенью была покрыта почти вся стена. Это и вызвало аллергию у членов семьи. Пришлось обращаться в специальные службы, чтобы уничтожить грибницу.
Почему в домах и квартирах возникает плесень
«Во всем виноваты споры», — говорит Мелькумов. Это клетки грибов, которые нужны для размножения. Миколог объясняет, что споры плесени практически невесомые, поэтому с потоком воздуха они легко разносятся, в том числе и по помещениям.
Аллерголог клиник DocDeti и DocMed Селма Аршба отмечает, что плесень может попасть в дома и квартиры через открытые дверные проемы, окна, вентиляционные отверстия, системы отопления и кондиционирования. Споры легко прикрепляются к одежде и обуви людей, к шерсти домашних питомцев. Врач добавляет, что многие строительные материалы (картон, потолочная плитка, древесина, изделия из дерева и другие) содержат питательные вещества, которые способствуют росту плесени.
Когда спора попадает на какую-то поверхность, например пол, стены или обои, она начинает постепенно прорастать. Так образуется основная часть гриба — вегетативное тело, и сетевидные структуры — гифы, которые сплетаются в грибницу (мицелий). Как правило, невооруженным глазом их не видно.
Мелькумов отмечает, что именно на грибнице появляются так называемые органы спороношения — видимая часть плесени, на которой созревают споры. Они могут быть разных цветов в зависимости от вида гриба: белыми, черными (такая плесень часто возникает в ванных комнатах), синими (как правило, такой грибок появляется на отсыревшей древесине), зелеными, желтыми или голубыми. А вот розовый налет, похожий на плесень, образуется не из-за грибов, а из-за бактерий.
«Когда мы видим плесень — это уже следствие проблемы, — объясняет Мелькумов. — Если плесень появляется на хлебе, у многих есть соблазн отрезать кусок с видимым повреждением и съесть оставшуюся часть. На самом деле употреблять в пищу такой хлеб нельзя: если образовалось спороношение, значит, гриб уже распространил свои гифы внутри буханки».
По словам миколога, чтобы плесень распространялась, нужна влажная среда: протекающая крыша или трубы, остатки воды на подоконниках и в ванной. А также отсутствие вентиляции, редкие проветривания, которые могли бы просто унести споры из квартиры до того, как они прорастут.
Аршба добавляет, что обычно грибок развивается при влажности воздуха выше 60%. Также благоприятные условия для плесени — темнота и температура воздуха ниже 20 °С.
«Если в доме сухо и хорошая вентиляция, споры грибка не представляют опасности — они не будут разрастаться. А если сыро, появятся пятна плесени», — подчеркивает аллерголог.
Плесень под микроскопом Фото: Voskanyanhaik / wikipedia.org
Плесень под микроскопом Фото: Voskanyanhaik / wikipedia.org Как плесень влияет на здоровье людей
Минздрав России делит все патогенные грибки на четыре группы, в зависимости от степени их опасности для человека:
- группа I — возбудители особо опасных инфекций;
- группа II — возбудители глубоких микозов человека;
- группа III — организмы, вызывающие системные микозы при снижении иммунного статуса человека;
- группа IV — возбудители поверхностных микозов.
Наиболее опасные для здоровья — патогенные грибки из первой и второй групп. Вызванные ими заболевания могут приводить к летальному исходу. Из тех видов плесени, которые появляются в домах, наиболее опасные — аспергилл желтый (Aspergillus flavus, относится к третьей группе) и аспергилл черный (Aspergillus niger, относится к четвертой группе). Эти грибки могут вызывать микозные заболевания при проникновении в тело человека, в том числе через вдох.
«Есть выражение “проклятие Тутанхамона”. Люди, которые вскрыли гробницу фараона, со временем начали умирать по непонятным причинам. Ученые предположили, что при входе в пирамиду люди вдыхали споры аспергилла. Постепенно плесневые грибы стали проникать в их органы и распространяться по кровотоку», — рассказывает Мелькумов.
Аспергилл может вызывать тяжелые респираторные заболеванияВ частности, хронический легочный аспергиллез, который может приводить к кровохарканию и кровотечению в легком. По словам Мелькумова, опасность таких заболеваний в том, что человек долго не замечает, что он чем-то заразился. За это время грибок распространяется, появляются первые симптомы: кашель, повышение температуры, головная боль.
Зеленая плесень из рода пенициллов (Penicillium) может вызывать пенициллиоз. Заболевание проявляется, если у человека снижен иммунитет.
Споры плесени также могут вызывать аллергические реакции, рассказывает Аршба. Среди них — бронхиальная астма, аллергический ринит.
«Аллергия на плесень похожа на другие виды респираторных реакций, таких как аллергия на пыльцу или домашних животных, — отмечает врач. — Она может вызывать чихание, насморк или заложенность носа, зуд, слезящиеся глаза, удушье, кашель, кожные высыпания».
Для того чтобы развились симптомы аллергии, важны два фактора:
- предрасположенность организма человека;
- характеристики аллергена: он должен быть достаточно большим по размеру, чтобы вызывать иммунный ответ организма.
У людей с бронхиальной астмой воздействие грибков может усугубить респираторные симптомы. Тяжелые реакции часто возникают у тех, кто сталкивается с большим количеством плесени на работе, — например, у фермеров, взаимодействующих с заплесневелым сеном.
Аршба отмечает, что в группе риска также люди с заболеваниями или ослаблением иммунной системы, например:
- пациенты после трансплантации органов и стволовых клеток;
- люди, находящиеся на химиотерапии или принимающие лекарства, ослабляющие иммунную систему;
- пациенты с онкологическими заболеваниями крови.
Для детей плесень может быть опаснее, чем для взрослых: споры быстрее проникают в организм и вызывают более тяжелую аллергическую реакцию. Домашние животные тоже восприимчивы к грибку. Они могут не только вдохнуть, но и слизать споры плесени. К тому же питомцы часто ходят и спят в квартире в местах, труднодоступных для уборки, где может расти плесень.
Если человек замечает, что в его доме появилась плесень — и у него начались симптомы аллергии или грибка, нужно обратиться за медицинской помощью.
 Плесень под микроскопом Фото: Dimineataperacoare / wikipedia.org
Плесень под микроскопом Фото: Dimineataperacoare / wikipedia.org Что делать, чтобы плесень не появлялась
Эксперты отмечают, что главное правило для профилактики грибков в доме — контроль влажности. По словам Аршбы, она должна быть не выше 50% в течение всего дня. Во влажные месяцы аллерголог советует использовать кондиционер или осушитель.
Среди других принципов, защищающих дом от плесени, врач называет:
- своевременный ремонт протекающих крыш, окон и труб;
- тщательную очистку и сушку помещений (например, после затопления);
- вентиляцию душевой, прачечной и кухонной зоны.
Аршба также советует не использовать ковер в помещениях, где может быть много влаги (например, в ванных комнатах или подвалах): на нем может оседать влага.
Мелькумов отмечает, что необходимо проветривать помещения, чтобы споры могли улететь из квартиры. Кроме того, важно регулярно делать влажную уборку, говорит эксперт. Это помогает убирать споры с поверхностей.
 Плесень под микроскопом Фото: Alexander Pletnev / Wikipedia.org
Плесень под микроскопом Фото: Alexander Pletnev / Wikipedia.org Как бороться с плесенью
С грибком можно попробовать справиться самостоятельно, только если размер пораженного участка (например, стены или мебели) не больше одного квадратного метра. Меры нужно принимать как можно скорее, пока плесень не разрослась, особенно если речь идет о пористых материалах: древесине, гипсокартоне, бумаге.
«Заплесневелые предметы из жилых помещений лучше сразу удалить. Как только плесень начинает расти, например, на ковре, единственный способ решить проблему — его заменить. Если плесень обнаружена на обоях, их следует поменять, обработав стену профессиональными противогрибковыми средствами», — советует Аршба.
Грибок же на затирке между плиткой стоит удалить, а если это не поможет несколько раз, возможно, стоит подумать о замене затирки.
«Иногда кажется, что плесень на штукатурке можно снять наждачкой — и так полностью спасти свою комнату. На самом деле это не всегда работает, гриб может вернуться. Иногда сносят весь внутренний фасад, потому что плесень прорастает, и очень глубоко», — рассказывает Мелькумов.
По его словам, некоторые люди пробуют бороться с плесенью с помощью отбеливателей, спирта или перекиси. «Эти технологии абсолютно неэффективные, — говорит эксперт. — Плесень все равно продолжает расти. Другой способ — средства, содержащие хлор. Они приносят результат, но краткосрочный: через некоторое время плесень может появляться снова».
Аршба подчеркивает, что обработка плесени химическими веществами может быть в том числе опасной для человека. Особенно если смешивать несколько средств во время уборки«Самое опасное вещество — хлорка. В сочетании с другими веществами, кроме воды, она выделяет опасные газы, которые раздражают дыхательные пути, глаза, вызывают кашель. Смешивание хлорки с аммиаком или другими бытовыми чистящими средствами может привести к образованию опасных токсичных паров», — предупреждает врач.
Работающими способами Мелькумов называет и обработку пораженных участков фунгицидными препаратами — например, на основе меди или железа. Некоторые из них можно купить в специализированных магазинах, а некоторые доступны только службам санобработки. Они также могут использовать метод сушки, когда плесень нагревается с помощью специальных аппаратов. По словам миколога, этот способ тоже работает: при высоких температурах многие споры плесени погибают.
Важно помнить, что при обработке плесени в домашних условиях необходимо использовать защитные средства: перчатки, маски и защитные очки. Во время уборки следует проветривать помещение. А если в семье есть человек с аллергическими заболеваниями или ослабленной иммунной системой, ему желательно не находиться в квартире во время уборки и не участвовать в ней.
Если же в помещении большое количество плесени, важно обращаться в профессиональные клининговые службы, у которых есть опыт удаления плесени в зданиях и домах, говорит врач-аллерголог. Они смогут обработать помещение специальными защитными составами, продезинфицируют поверхности от спор грибков, просушат стены.
 Плесень под микроскопом Фото: Thomas Bresson / Wikipedia.org
Плесень под микроскопом Фото: Thomas Bresson / Wikipedia.org Что делать, если никакие средства не помогают
Бывают ситуации, когда плесень появляется снова и снова, вне зависимости от усилий жильцов. По словам управдома, журналиста и блогера Андрея Мужщинского, так происходит, когда в квартире или доме неисправна вентиляция либо промерзают стены. Ответственность за эти проблемы несет управляющая компания.
Пять лет назад Мужщинский въехал вместе с семьей в квартиру в Красноярске. Она была на последнем этаже.
«Первая же зима обнажила ворох проблем, — вспоминает управдом. — Углы в некоторых местах промерзали, батареи не грели, вентиляция не работала. Мы открыли окно и поднесли зажженную спичку к решетке в ванной. Движения воздуха не наблюдалось. В местах промерзания стала образовываться черная плесень».
Мужщинский написал обращение в управляющую компанию — потребовал, чтобы ее сотрудники проверили исправность вентиляции и зафиксировали проблемы в акте. «Забитую шахту они так и не нашли, но оборудовали новый вентиляционный вывод, благо последний этаж», — рассказывает управдом.
Он также потребовал от управляющей компании проверить температуру в квартире и сравнить с нормативами. Показатели были ниже положенных.
Чтобы решить проблему, в случае Андрея пришлось не только настраивать подвальные коммуникации — эта мера не помогла, тепло из квартиры все равно уходило. Он добился, чтобы сотрудники управляющей компании обследовали дом с помощью тепловизора. Оказалось, что нужно утеплить изнутри зимний холодильник, замазать дыру на фасаде дома, переварить общедомовую трубу отопления, идущую через квартиру, утеплить чердак над ней. На такие работы и на восстановление вентиляции ушел год. «Все это можно было сделать быстрее, если решать проблему только своими ресурсами. Но раз уж мы ежемесячно платим управляющей компании за содержание и ремонт общего имущества, [я решил, что] надо требовать с нее», — делится управдом.
Часто плесень появляется в аварийных домах, в которых есть большие трещины, разваливаются стены, текут трубы. Если жители считают, что дом аварийный, они могут обратиться в мэрию. Специальная комиссия должна решить, какой статус у дома. Предварительно можно заказать обследование технического состояния дома у специализированной организации — если та подтвердит ветхость здания, будет полезным приложить к обращению в мэрию этот документ.
Если дом признан аварийным, его должны снести, а жильцов — переселить. «Но в нашей российской действительности снос может затянуться на годы и даже десятилетия, — говорит Мужщинский. — В этом случае людям нужно проявить активность: обращаться в прокуратуру и суд».